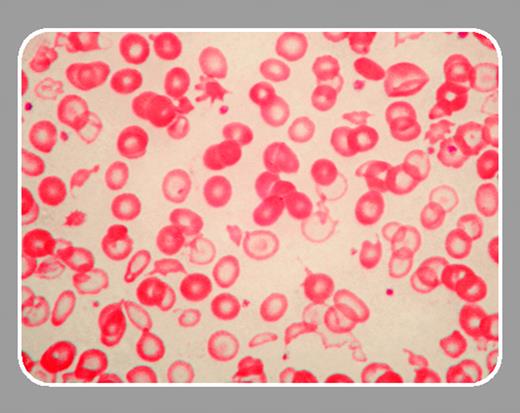
graphic

The myelodysplastic syndromes (MDSs) are a heterogeneous group of disorders characterized by ineffective hematopoiesis and a variable risk of transformation to acute leukemia. This heterogeneity, both at the phenotypic and molecular level, is underscored by 2 papers in the current issue of Blood. In the first of these, Steensma and colleagues (page 1518) describe a patient with MDS associated with acquired α-thalassemia. This rare syndrome, referred to as the α-thalassemia myelodysplasia syndrome (ATMDS), is characterized by hypochromic microcytic anemia, anisopoikilocytosis, markedly reduced α-globin chain synthesis, and substantial amounts (> 10%) of hemoglobin H (beta globin tetramers). While inherited α-thalassemia is typically due to deletions or point mutations affecting the duplicated α-globin genes on chromosome 16, ATMDS has been shown to be due to mutations in a gene called ATRX (alpha thalassemia/mental retardation syndrome X-linked homolog).1 This gene on the X chromosome encodes a chromatin-remodeling gene that regulates the expression of a number of genes, including the α-globin genes. Germ line mutations of ATRX have been described and cause a mild α-thalassemia syndrome associated with a mental retardation.2
In the current issue, Steensma and colleagues describe a man with mild anemia, marked microcytosis, hypochromia and anisopoikilocytosis, and bone marrow studies diagnostic of myelodysplastic syndrome (refractory cytopenia with multilineage dysplasia). Hemoglobin H inclusions were present at low levels (< 1%) in peripheral blood erythrocytes. Globin chain synthetic ratios were consistent with heterozygous α-thalassemia. Marrow chromosome studies revealed complex cytogenetic abnormalities. Fluorescence in situ hybridization (FISH) and Southern blot studies revealed a deletion larger than 1.9 Mb that removed the α-globin cluster from one chromosome 16. Thus, the α-thalassemia phenotype in this patient is due to the deletion of 2 of 4 α-globin genes (genotype αα/––). Interestingly, the red cell changes are more marked than those typically seen in heterozygous α-thalassemia. In addition, the presence of hemoglobin H is also unusual for heterozygous α-thalassemia. It seems likely that this somewhat more severe thalassemic phenotype is due to an interaction between the α-thalassemia deletion and the ineffective erythropoiesis characteristic of a myelodysplastic bone marrow. This is the first report of ATMDS due to deletion of the α-globin gene cluster rather than a mutation in the ATRX gene.
In a second paper, Gattermann and colleagues (page 1499) examined the role of a mitochondrial DNA mutation in MDS. The potential role for mitochondrial DNA in acquired MDS was suggested by the constitutional disorder, Pearson syndrome, in which sideroblastic anemia is accompanied by pancreatic dysfunction. In this disorder a number of deletions in mitochondrial DNA have been described.3 Studies of mitochondrial DNA in acquired MDS have suggested that mutations can be found in up to 50% of patients.4 Other investigators have found that mitochondrial DNA mutations are less widespread in acquired MDS.5 The significance of these mutations and their role in the pathogenesis of MDS remains a subject of ongoing investigation.
Gattermann and colleagues describe a patient with myelodysplastic syndrome (refractory anemia with excess blasts [RAEB]) who was found to have a somatic mutation of mitochondrial transfer RNA (tRNA) in bone marrow cells. Approximately 40% of the mitochondrial DNA molecules in the marrow contained this mutation. The mutation was present at a higher level in marrow and peripheral blood CD34+ cells than in unfractionated marrow. The mutation was not found in unfractionated peripheral blood leukocytes or in buccal mucosal cells. These findings suggested that marrow cells carrying the mitochondrial DNA mutation did not contribute to effective hematopoiesis. Thalidomide treatment resulted in improved red cell and platelet production and in a decrease in marrow blast percentage. Interestingly, there was a coincident decrease in the percentage of mutant mitochondrial DNA in the bone marrow. Hematopoietic colony assays were performed using CD34+ cells derived from marrow and peripheral blood. In all cases, mature hematopoietic colonies were composed entirely of cells containing thewild-type mitochondrial DNA. These findings indicate that this mitochondrial mutation was linked with a marrow maturation defect. A mutation in a mitochondrial transfer RNA would result in impaired mitochondrial protein synthesis and potentially dysfunction in the respiratory chain. This report provides evidence that mitochondrial DNA mutations may contribute to the ineffective hematopoiesis of MDS.

This feature is available to Subscribers Only
Sign In or Create an Account Close Modal